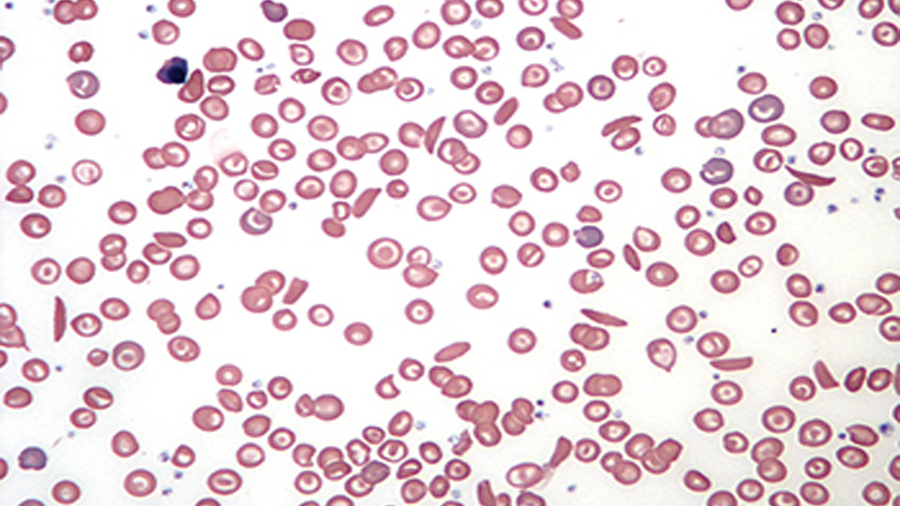

Images Of Blood Cells

Super Human Red Blood Cells Advanced Science News

Research Focuses On Targeted Drug Delivery Via Red Blood Cells To Treat Arthritis Duke Health Referring Physicians

Red Blood Cells Catalyze Polymerization

See White Blood Cells Move In 3 D Imaging Youtube

In Sickle Cell Disease White Blood Cells Regulate Fetal Hemoglobin

New Synthetic Red Blood Cells Are Even Better Than The Real Thing


White Blood Cells Hd Stock Images Shutterstock

White Blood Cells Hd Stock Images Shutterstock

10 High Red Blood Cell Count Polycythemia Symptoms Treatment

White Blood Cells Swimming Along The Red Blood Cells Ash Clinical News

A New Technology That Uses Red Blood Cells To Deliver Antigens Tech Explorist
:focal(1832x1227:1833x1228)/https://public-media.si-cdn.com/filer/49/e0/49e03f85-6664-4980-a5f1-1974838f3717/gettyimages-179796759.jpg)
Harmful Bacteria Masquerade As Red Blood Cells To Evade The Immune System Science Smithsonian Magazine

How The Spleen Filters Blood Mit News Massachusetts Institute Of Technology

Five Ways To Increase White Blood Cell Count With Tcm Tim Eng Lac Acupuncture Chinese Medicine

A Synthetic Red Blood Cell That S Better Than The Real Thing Cell And Molecular Biology

Covid 19 Research Roundup Blood Cell Damage Poor Lung Function Underreporting In The Us Technology News Firstpost

U M Researchers Discover How Distracting A White Blood Cell May Stop Covid 19 Deaths Dbusiness Magazine

Blood Cell Images Stock Photos Vectors Shutterstock

High Performance Density Gradient Media For Purification Of Leukocytes From Blood

An Overview Of Red Blood Cell Lysis

Red Blood Cells Mapcards Net
2 652 Red Blood Cell Photos And Premium High Res Pictures Getty Images

Red Blood Cells In Animals Circulatory System Merck Veterinary Manual
Blood And Bone Marrow Macmillan Cancer Support

Red Blood Cells Meets Physics Physics Meet Red Blood Cells

Mapping The Body Red Blood Cells Health Wellbeing The Guardian
/understanding-white-blood-cells-and-counts-2249217_final-0587074073ce4709b41e42a08db0f596.gif)
Types And Function Of White Blood Cells Wbcs
How To Improve Your White Blood Cells Naturally
8 457 White Blood Cell Stock Photos Pictures Royalty Free Images Istock

Janitorial System In Red Blood Cells Discovered

Red Blood Cells The Franklin Institute
/blood-flowing-in-veins-red-and-white-blood-cells--1136593482-f5439d34be7c40a1bb7a2330b036b7e1.jpg)
Chemotherapy And Low White Blood Cell Wbc Counts
Sphingolipid Metabolism A Potential Therapeutic Target In Sickle Red Blood Cells

New Types Of Blood Cells Discovered

Blood Function And Composition Healthengine Blog

How Our Red Blood Cells Keep Evolving To Fight Malaria
/red-blood-cells-in-bloodstream-562597275-5a031b88482c52001adafd40.jpg)
12 Interesting Facts About Blood
:background_color(FFFFFF):format(jpeg)/images/library/13191/histology-blood_english.jpg)
Types Of Blood Cells Kenhub
1
/Blood-cells-58ac6c8c3df78c345b5a9182.jpg)
What Red Blood Cell Indices Tell You About Your Health

Xconomy Rubius Adds 1m To Ready Tests Of Red Blood Cells As Drug Carriers
2 147 White Blood Cell Photos And Premium High Res Pictures Getty Images

White Blood Cells In Animals Circulatory System Merck Veterinary Manual
/red_blood_cells_1-57b20c583df78cd39c2f8e15.jpg)
Red Blood Cells Function And Structure

Skin Cells Transformed Into Blood Medical Research The Guardian
22 776 Blood Cell Stock Photos Pictures Royalty Free Images Istock

What Does A Low White Blood Cell Count Mean The Answer Isn T Simple

High White Blood Cell Count Causes Types

How Red Blood Cells Get Their Dimples The Scientist Magazine

Attack On Red Blood Cells A Prime Suspect In Covid S Debilitating Effects

The Amazing Flexibility Of Red Blood Cells Eurekalert Science News

White Blood Cells Launch Dna Webs To Warn Of Invaders Science as

How To Increase Or Decrease Red Blood Cells Selfhacked

Blood Red Blood Cells Erythrocytes Britannica

Blood Cell Wikipedia

How Our Red Blood Cells Keep Evolving To Fight Malaria

Healthy Red Blood Cells Flow In An Ordered Pattern Unlike Their Diseased Counterparts

Blood Constituents Physical Properties Sources Functions Of Plasma Proteins Science Online
Sickle Cell Disease Johns Hopkins Medicine

The Connection Between Severe Covid 19 And White Blood Cell Counts

Definition Of Erythrocyte Nci Dictionary Of Cancer Terms National Cancer Institute

Structure And Function Of Blood Biology For Majors Ii

Turning Red Blood Cells Into Cargo Ships Science as
2 652 Red Blood Cell Photos And Premium High Res Pictures Getty Images

Blood Cell Formation Description Process Types Of Blood Cells Britannica

Intercepting Genes To Study Red Blood Cells

Red Blood Cells And Mercury Nih Director S Blog

Could Engineered Red Blood Cells Be An Effective Antiviral Against Sars Cov 2

Types Of Blood Cells With Their Structure And Functions

Erythropoiesis Wikipedia

Overview Of Blood

Helping Blood Cells To Regenerate After Radiation Therapy
Q Tbn And9gctluy5h1wz Hcvuogqamztw0a2awamcwwsxp Ryliirwybuwycv Usqp Cau

Neocytolysis When Young Red Blood Cells Die First
Facts About Blood University Hospitals

Red Blood Cells Photos Royalty Free Images Graphics Vectors Videos Adobe Stock

Apheresis Platelets Plasma And Double Red Blood Cells Stanford Blood Center

Liquid Crystals Give Red Blood Cells Mechanical Squeeze Cornell Chronicle

Definition Of Blood Stem Cell Nci Dictionary Of Cancer Terms National Cancer Institute

New Way Of Measuring White Blood Cell Function Offers Better Insights To Help Patients With Sepsis Clinical Lab Manager

Genetic Code Of Red Blood Cells Discovered Lund University

White Blood Cells Use Molecular Breaststroke To Swim
Q Tbn And9gcrwvin37xmhjedfo5toudjwbrkipj43ng4cg7wanboffqbfggcj Usqp Cau

Super Human Red Blood Cells Hide Drugs From Immune System Attack

Red Blood Cells Abo Sdix Llc

Shape Shifting Red Blood Cells Respond To Shear Forces Physics World

Rediscovering Red Blood Cells Revealing Their Dynamic Antigens Store And Its Role In Health And Disease Intechopen
8 457 White Blood Cell Stock Photos Pictures Royalty Free Images Istock

Definition Of White Blood Cell Nci Dictionary Of Cancer Terms National Cancer Institute

White Blood Cell Definition Function Britannica

Invasion Of Red Blood Cells Rbcs By Malaria Parasites Medmastery
Red Blood Cells White Blood Cells And Platelets Sem Stock Image C032 0866 Science Photo Library

Structure And Function Of Blood Biology For Majors Ii

Human Anatomy Blood Cells Plasma Circulation And More

Lifeline Introduces Human Blood Cells

Memorial Regional Health Blood Cells Reveal Much About Overall Health Simple Blood Cell Count An Important Lab Test Craigdailypress Com

Scientists Discover New Process Shaping Red Blood Cell Development

How Red Blood Cells Harm Cardiovascular Health In Diabetes
Q Tbn And9gcsysfpulcppnan0vjkss68ca2phhzjdb3bd5rljdjhr1cleq Nf Usqp Cau

Hematopoiesis Definition Where It Occurs Process And Types

Biotech Startup Rubius Raises 1m To Develop Red Blood Cell Technology The Boston Globe

Super Human Red Blood Cells Could Revolutionise Drug Delivery

Blood Is The Next Critical Tool In The Coronavirus Fight Here S Why

Diffusion And Red Blood Cells